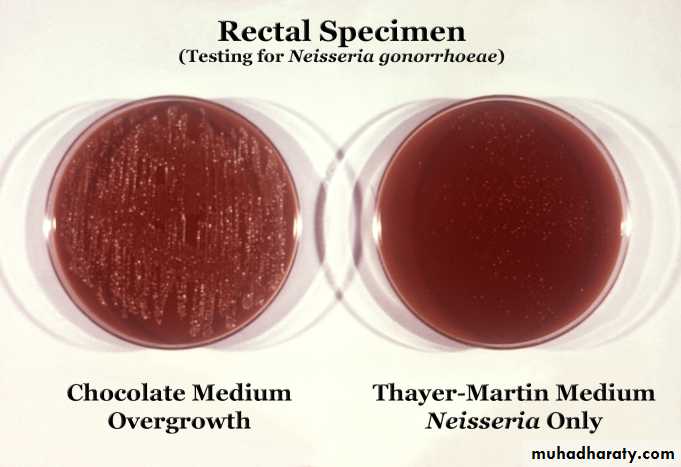

3rd-year classPractical Pharmacology2010-2011
Lab.12Problem solving
AntimicrobialPROBLEM.1
A 20 years old manual worker developed severe cellulitis of the hand with axillary lymph node enlargement.Try to chose your personal antibiotic for this patient.Would this treatment change if the patient has penicillin allergy?Problem.2
A 20 years old male had gonorrhoea. Both tetracycline and amoxycillin(with probenecid)were prescribed for him to be taken simultaneously. The student should give his account on the type of drugs used,the type of dose in treatment of GC,and the alternative drugs that can be used in its treatment.Problem.3
A 40 years old lady admitted to hospital for acute pyelonephritis. she has a history of repeated similar attacks. On the seventh day she developed difficulty in hearing. Explain the possible cause of this side effect on the basis of pharmacokinetic alteration of the drugs by the disease.Problem.4
A 35 years old man presented with high fever,headache,loss of appetite. Inspite of regular use of paracetamol he was still running high fever. Typhoid fever was suspected because he has a young sister having the disease two weeks ago. Widal test was performed twice and a rising titer was reported. Ciprofloxacin was given in a dose of 500 mg twice daily.a. Is that a right choice?
b. What alternative drugs can be used.c. Are the dose and duration of treatment important?